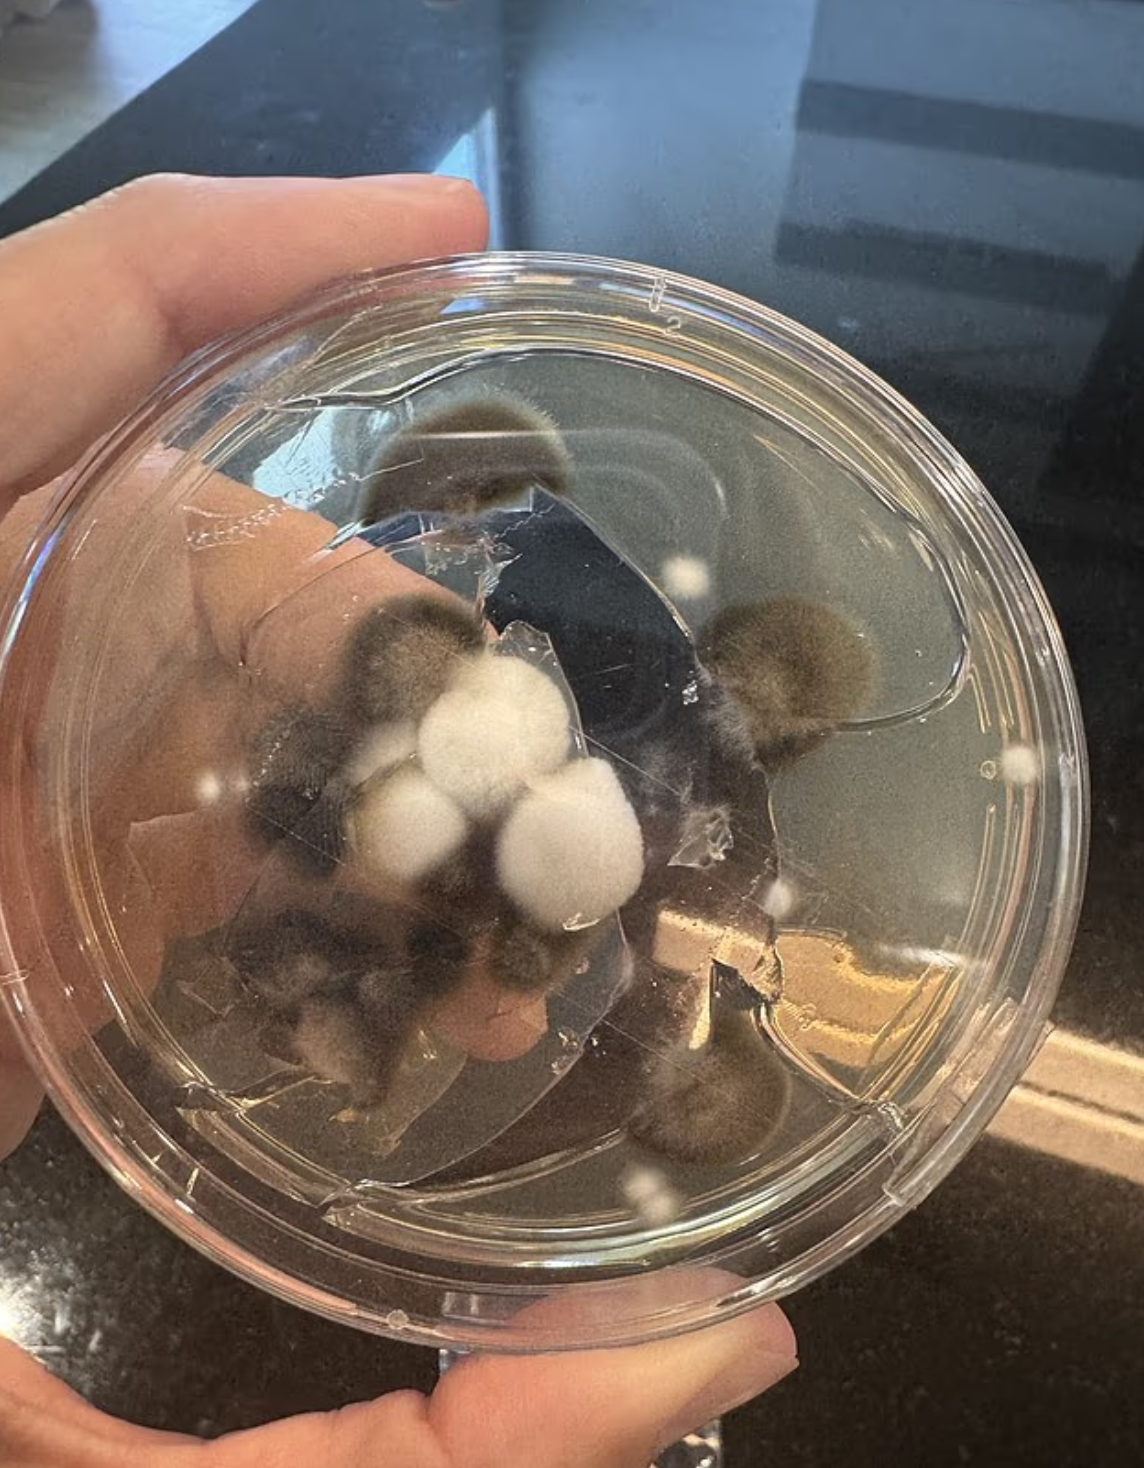

【腎癌/誤診/確診/黴菌/家電/傷腎】據英國《每日郵報》報道,在2022年2月,來自美國俄克拉荷馬州的38歲兩孩之母Schayene Silva搬進新家,她當時感到非常興奮。但僅數月後,她開始出現嚴重胃灼熱、咳嗽和嘔吐。
她因擔心去看醫生,對方稱腰痛只是脹氣造成。惟其疼痛情況沒有改善,她在隨後近3年間分別向7名醫生求診,但所有醫生都聲稱是消化問題,亦有醫生指她「太年輕」,不可能得癌症。

確診一期腎癌
至第8名醫生在2024年10月建議Schayene進行MRI掃描,結果顯示她的左腎有一個腫塊,醫生確定是一期透明細胞腎癌,該是美國最常見的腎癌類型。雖然大多數腎癌病因不明,但吸煙和飲酒等生活習慣會導致DNA損傷,進而引發腫瘤。Schayene當時向醫生解釋她既不吸煙也不酗酒,醫生則表示這純粹是「運氣不好」。

Schayene於2025年4月接受腫瘤切除手術,但她決心找出病因,以防止腫瘤復發。她在網上搜尋可能原因,並決定對家中進行黴菌檢測,因黴菌會產生與器官損傷和某些癌症相關的毒素。
體內黴菌毒素超標10倍
最初檢測結果一切正常,至Schayene想到要檢查製冰機,她拆開外殼後,發現機器長滿黴菌,令她懷疑腎癌的罪魁禍首可能是家中黴菌。進一步檢測顯示,Schayene體內的赭麴毒素含量是正常水平的10倍,而赭麴毒素是由麴菌和青黴菌產生的毒素。世界衛生組織表示,赭麴毒素最顯著的影響是腎臟損傷,該毒素也可能對胎兒發育和免疫系統產生影響。
據報透明細胞腎細胞癌起源於幫助過濾血液中廢物的細胞,約佔腎癌病例的10分之8。此疾病通常影響老年人,平均確診年齡為65歲。確切原因尚不清楚,但越來越多證據表明,某些黴菌產生的毒素可能增加患病風險。
黴菌通常只需1、2天就能在洗碗機和製冰機等高濕度區域開始生長,但可能需要數周或數月才會出現更明顯的跡象,如異味和可見的污漬。
Schayene術後已擺脫癌症,並停止使用製冰機,她此後沒有再出現胃灼熱、噁心、脫髮和焦慮等症狀。
「一旦脫離感染環境,身體就知道如何自癒。我知道醫生錯了,所以我沒有放棄,我覺得我已戰勝它。」
【延伸閱讀】
腎癌 | 不煙不酒確診腎癌 揭體內藏永久化學物 5大源頭家中常見一款廚具高危 3招排毒一年後恢復正常



